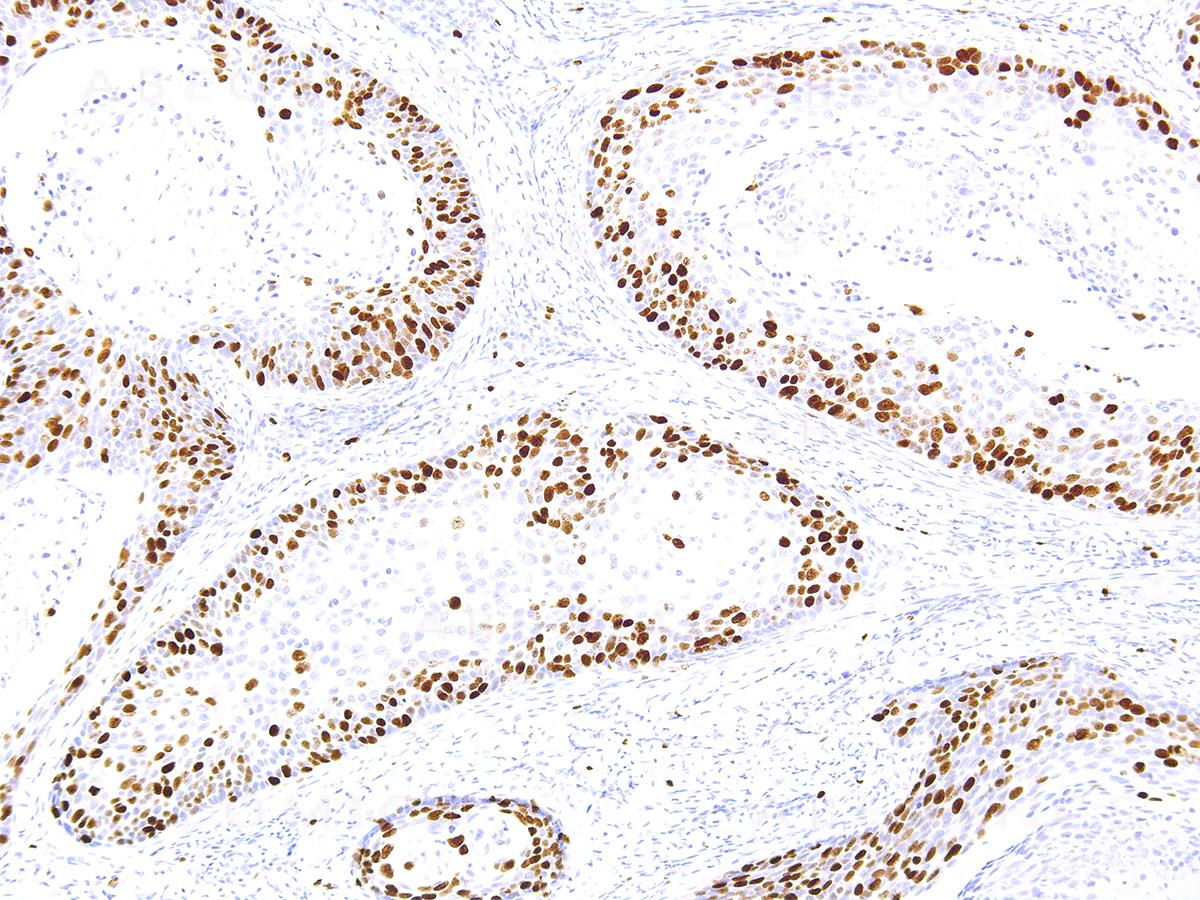

Anti-Ki-67 Monoclonal Antibody (Clone:IHC067)-Ready to Use
Figure 1: Immunohistochemical analysis of Ki-67 (Clone: IHC067) on Cervical Cancer - 10X
Roll over image to zoom in
Shipping Info:
For estimated delivery dates, please contact us at [email protected]
Amount : | 7 ml |
Isotype : | Mouse IgG2b |
Purification : | Protein A/G Chromatography |
Content : | Tris Buffer, pH 7.3 - 7.7, with 1% BSA and <0.1% Sodium Azide |
Storage condition : | Store at 2°C - 8°C. Do not freeze. |
"Ki-67 is a nuclear, non-histone protein that is expressed only during active phases of the cell cycle (G1, S, G2 and M), but not in the resting phases (G0 and G1 early phase). Although the antigen has also been associated with ribosomal RNA transcription, it is strongly linked to cell proliferation and has thus been indicated as an effective marker in grading the proliferation rate of tumors, including those of the brain, breast, cervix, and prostate."
This product is available in ready to use format, hence no dilution is required.
For Research Use Only. Not for use in diagnostic/therapeutics procedures.
Subcellular location: | Chromosome, Nucleus, Nucleus |
Post transnational modification: | Phosphorylated. Hyperphosphorylated in mitosis (PubMed:10502411, PubMed:10653604). Hyperphosphorylated form does not bind DNA. |
BioGrid: | 110434. 63 interactions. |
There are currently no product reviews
|